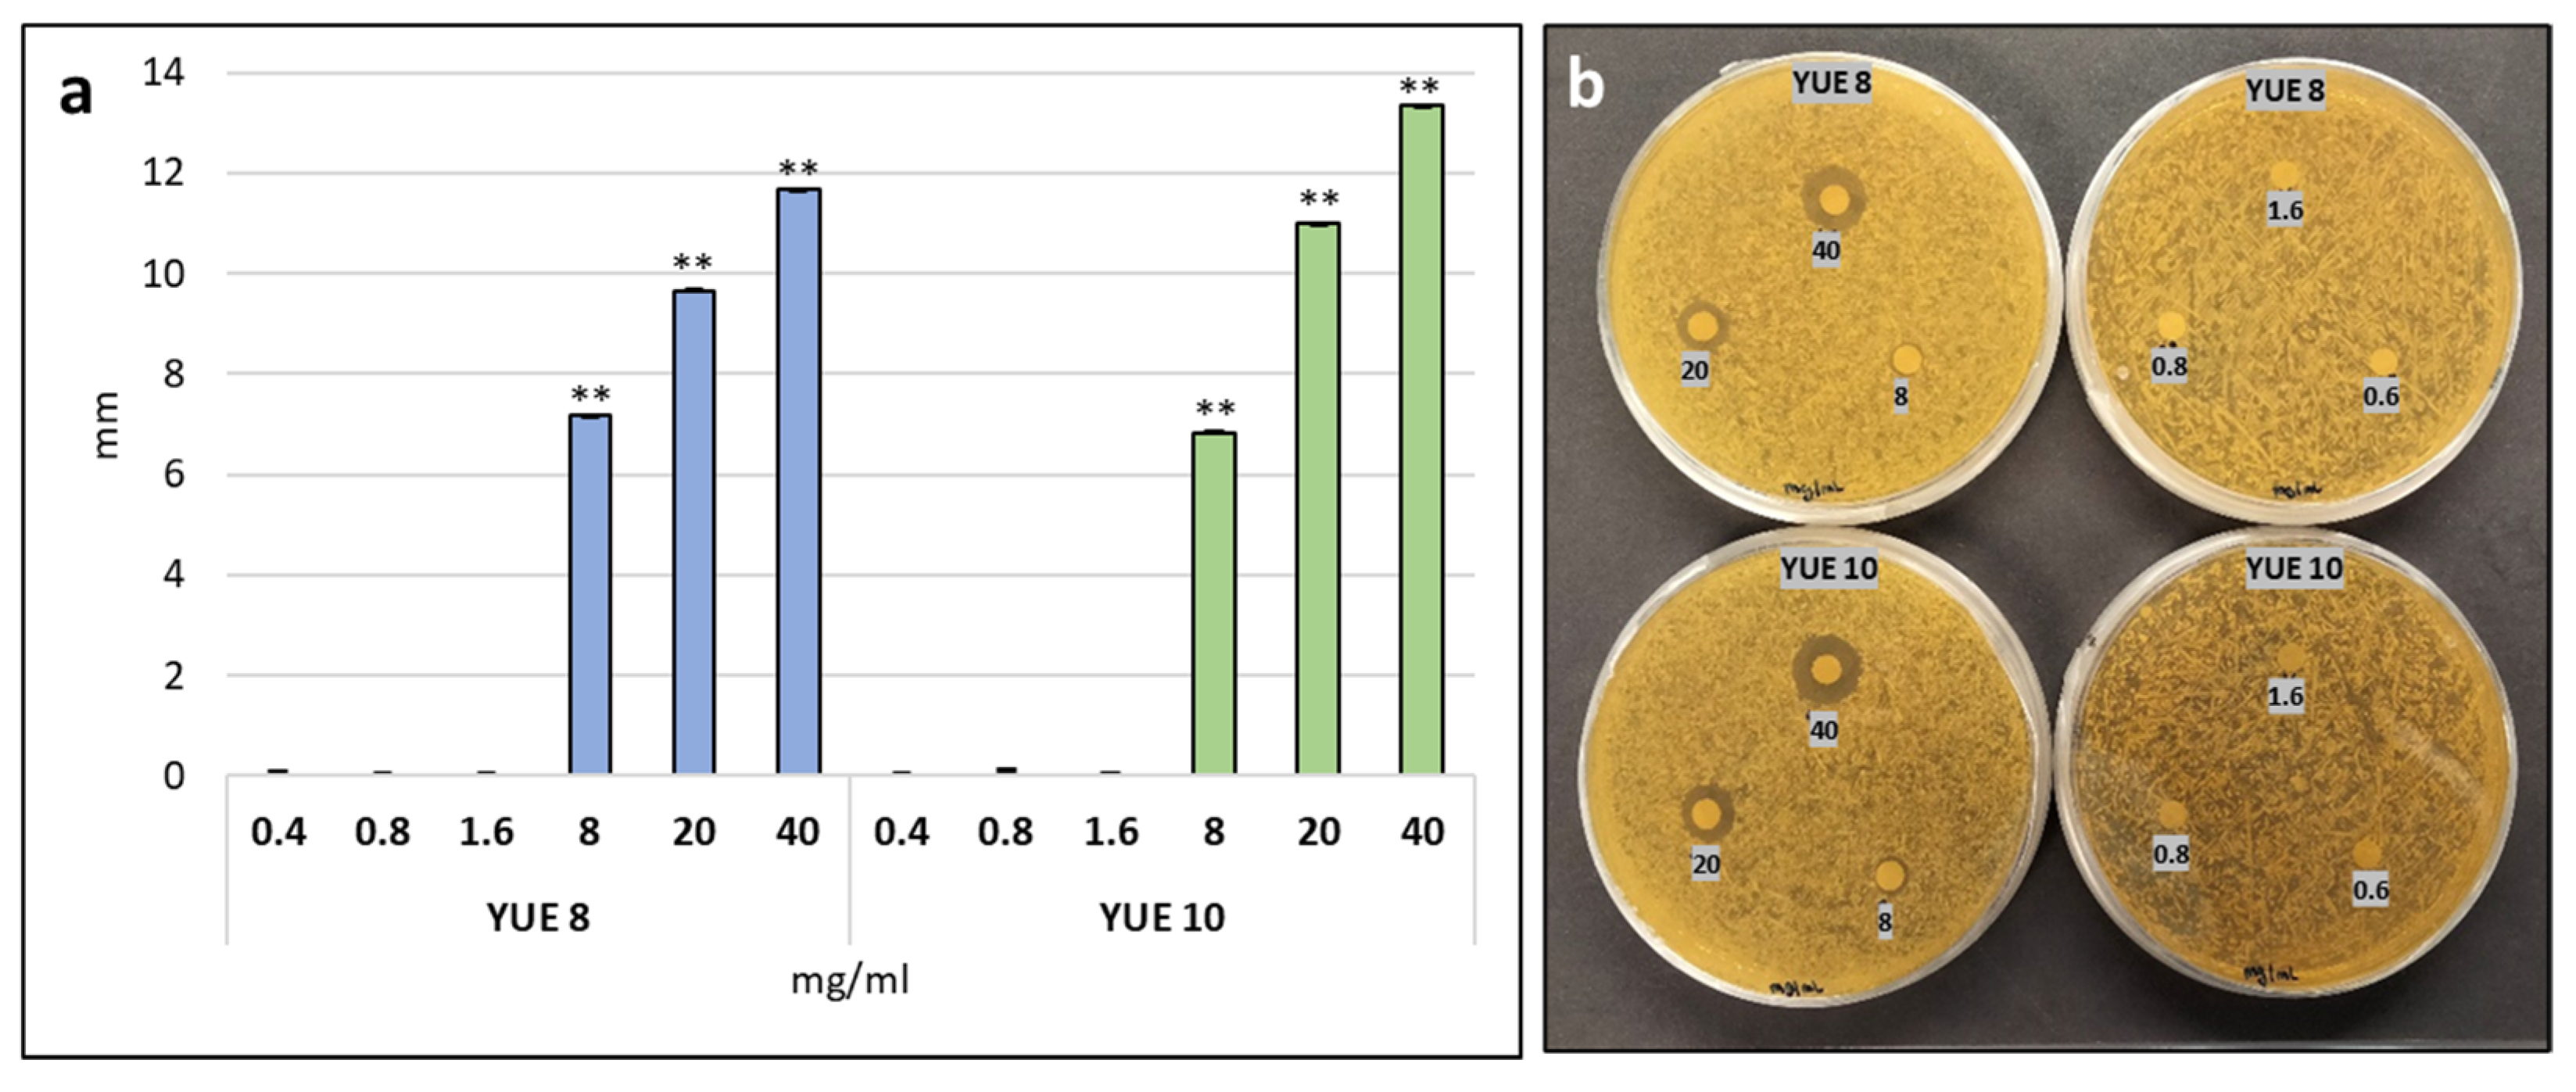
Plants 12 00274 g005

Use of Yucca (Yucca schidigera) Extracts as Biostimulants to Promote Germination and Early Vigor and as Natural Fungicides
Abstract
1. Introduction
2. Results
2.1. Evaluation of the Effect of Yucca Extracts on Germination and Early Development
2.2. Effect of Yucca Extracts on Improving Abiotic Stress Resistance
2.3. Effect of Yucca Extracts on Physiological Parameters in Arabidopsis
2.4. Characterization of the Fungicide Effect of Yucca Extracts
3. Discussion
4. Conclusions
5. Materials and Methods
5.1. Yucca Plant Extracts
5.2. Seed Germination, Plant Media and Growth Conditions
5.3. Establishment of the Toxic Dose of Yucca Extracts and the Optimal Concentration of the Abiotic Stressor
5.4. Treatment of Arabidopsis Seedling with Yucca Biostimulant under Saline and Osmotic Conditions
5.5. Antibiogram
5.6. Statistical Analysis
Author Contributions
Funding
Institutional Review Board Statement
Informed Consent Statement
Data Availability Statement
Conflicts of Interest
References
- IPCC Climate Change and Land Ice. Special Report on Climate Change, Desertification, Land Degradation, Sustainable Land Management, Food Security, and Greenhouse Gas Fluxes in Terrestrial Ecosystems; Summary for Policymakers; IPCC: Geneva, Switzerland, 2017; ISBN 9789291691548. [Google Scholar]
- Ma, Y.; Dias, M.C.; Freitas, H. Drought and Salinity Stress Responses and Microbe-Induced Tolerance in Plants. Front. Plant Sci. 2020, 11, 591911. [Google Scholar] [CrossRef]
- Ghazghazi, H.; Riahi, L.; Yangui, I.; Messaoud, C.; Rzigui, T.; Nasr, Z. Effect of Drought Stress on Physio-Biochemical Traits and Secondary Metabolites Production in the Woody Species Pinus Halepensis Mill. At a Juvenile Development Stage. J. Sustain. For. 2022, 41, 878–894. [Google Scholar] [CrossRef]
- Yigit, N.; Sevik, H.; Cetin, M.; Kaya, N. Determination of the Effect of Drought Stress on the Seed Germination in Some Plant Species. In Water Stress in Plants; IntechOpen: London, UK, 2016; ISBN 978-953-51-2621-8. [Google Scholar]
- Kaymakanova, M. Effect of Salinity on Germination and Seed Physiology in Bean (Phaseolus vulgaris L.). Biotechnol. Biotechnol. Equip. 2009, 23, 326–329. [Google Scholar] [CrossRef]
- Queiroz, M.S.; Oliveira, C.E.S.; Steiner, F.; Zuffo, A.M.; Zoz, T.; Vendruscolo, E.P.; Silva, M.V.; Mello, B.F.F.R.; Cabral, R.C.; Menis, F.T. Drought Stresses on Seed Germination and Early Growth of Maize and Sorghum. J. Agric. Sci. 2019, 11, 310. [Google Scholar] [CrossRef]
- Patanè, C.; Saita, A.; Sortino, O. Comparative Effects of Salt and Water Stress on Seed Germination and Early Embryo Growth in Two Cultivars of Sweet Sorghum. J. Agron. Crop Sci. 2013, 199, 30–37. [Google Scholar] [CrossRef]
- Qayyum, A.; Razzaq, A.; Ahmad, M.; Jenks, M.A. Water Stress Causes Differential Effects on Germination Indices, Total Soluble Sugar and Proline Content in Wheat (Triticum aestivum L.). Genotypes. Afr. J. Biotechnol. 2011, 10, 14038–14045. [Google Scholar] [CrossRef]
- Khajeh-Hosseini, M.; Powell, A.A.; Bingham, I.J. The Interaction between Salinity Stress and Seed Vigour during Germination of Soyabean Seeds. Seed Sci. Technol. 2003, 31, 715–725. [Google Scholar] [CrossRef]
- Marschner, H. Mineral Nutrition of Higher Plants; Academic Press: Cambridge, MA, USA, 1995; ISBN 9780080571874. [Google Scholar]
- Du Jardin, P. Plant Biostimulants: Definition, Concept, Main Categories and Regulation. Sci. Hortic. 2015, 196, 3–14. [Google Scholar] [CrossRef]
- Colla, G.; Rouphael, Y. Biostimulants in Horticulture. Sci. Hortic. 2015, 196, 1–2. [Google Scholar] [CrossRef]
- Bhupenchandra, I.; Chongtham, S.K.; Devi, E.L.; Ramesh, R.; Choudhary, A.K.; Salam, M.D.; Sahoo, M.R.; Bhutia, T.L.; Devi, S.H.; Thounaojam, A.S.; et al. Role of biostimulants in mitigating the effects of climate change on crop performance. Front. Plant Sci. 2022, 13, 967665. [Google Scholar] [CrossRef]
- Deolu-Ajayi, A.O.; van der Meer, I.M.; van der Werf, A.; Karlova, R. The power of seaweeds as plant biostimulants to boost crop production under abiotic stress. Plant Cell Environ. 2022, 45, 2537–2553. [Google Scholar] [CrossRef] [PubMed]
- Cheeke, P.R. Actual and Potential Applications of Yucca Schidigera and Quillaja Saponaria Saponins in Human and Animal Nutrition. In Saponins in Food, Feedstuffs and Medicinal Plants; Springer: Dordrecht, The Netherlands, 2000; pp. 241–254. [Google Scholar]
- Bishop, J. Yuccas in Cultivation. Br. Cactus Succul. J. 1994, 12, 138–143. Available online: https://www.jstor.org/stable/42793230 (accessed on 5 January 2023).
- Villarino, L.; Castillo, J.; Pena, G. Mechanization of Yucca Cultivation. In Proceedings of the Conferencia Cientifica del Instituto de Investigaciones de Mecanizacion Agropecuaria, Ciudad de La Habana, Cuba, 26–27 November 1985. [Google Scholar] [CrossRef]
- Layard, E.L. Yuccas under Cultivation. Nature 1880, 22, 606–607. [Google Scholar] [CrossRef]
- Bingham, R.; Bellew, B.A.; Bellew, J.G. Yucca Plant Saponin in the Management of Arthritis. J. Appl. Nutr. 1975, 27, 45–51. Available online: https://agris.fao.org/agris-search/search.do?recordID=US201303081700 (accessed on 5 January 2023).
- Cheeke, P.R.; Piacente, S.; Oleszek, W. Anti-Inflammatory and Anti-Arthritic Effects of Yucca Schidigera: A Review. J. Inflamm. 2006, 3, 6. [Google Scholar] [CrossRef]
- Lortkipanidze, R.; Tvalodze, S. Healing properties of Yucca gloriosa and its cultivation perspectives in agro-ecological environment of imereti. Sci. Rev. 2021, 3, 1–3. [Google Scholar] [CrossRef]
- Piacente, S.; Montoro, P.; Oleszek, W.; Pizza, C. Yucca Schidigera Bark: Phenolic Constituents and Antioxidant Activity. J. Nat. Prod. 2004, 67, 882–885. [Google Scholar] [CrossRef]
- Valencia del Toro, M.E.; Ramírez-Ortiz, G.; Flores-Ramírez, M.R.; Costa-Manzano, F.; RobleMartínez, M.E.; Garín-Aguilar, H.; Leal-Lara, H. Effect of Yucca schiedigera bagasse as substrate for oyster mushroom on cultivation parameters and fruit body quality. Rev. Mex. Ing. Química 2018, 17, 835–846. Available online: http://rmiq.org/ojs311/index.php/rmiq/article/view/11/65 (accessed on 5 January 2023). [CrossRef]
- Cheeke, P.; Otero, R. Yucca, Quillaja May Have Role in Animal Nutrition. Feedstuffs 2005, 77, 11–14. [Google Scholar]
- Katsunuma, Y.; Nakamura, Y.; Toyoda, A.; Minato, H. Effect of Yucca Shidigera Extract and Saponins on Growth of Bacteria Isolated from Animal Intestinal Tract. Nihon Chikusan Gakkaiho 2000, 71, 164–170. [Google Scholar] [CrossRef]
- Wang, Y.; McAllister, T.A.; Yanke, L.J.; Cheeke, P.R. Effect of Steroidal Saponin from Yucca Schidigera Extract on Ruminal Microbes. J. Appl. Microbiol. 2000, 88, 887–896. [Google Scholar] [CrossRef]
- Adegbeye, M.J.; Elghandour, M.Y.; Monroy, J.C.; Abegunde, T.O.; Salem, A.Z.M.; Barbabosa-Pliego, A.; Faniyi, T.O. Potential Influence of Yucca Extract as Feed Additive on Greenhouse Gases Emission for a Cleaner Livestock and Aquaculture Farming—A Review. J. Clean. Prod. 2019, 239, 118074. [Google Scholar] [CrossRef]
- Mao, H.L.; Wang, J.K.; Zhou, Y.Y.; Liu, J.X. Effects of Addition of Tea Saponins and Soybean Oil on Methane Production, Fermentation and Microbial Population in the Rumen of Growing Lambs. Livest. Sci. 2010, 129, 56–62. [Google Scholar] [CrossRef]
- Serrano, R.; Mulet, J.M.; Rios, G.; Marquez, J.A.; de Larrinoa, I.F.; Leube, M.P.; Mendizabal, I.; Pascual-Ahuir, A.; Proft, M.; Ros, R.; et al. A Glimpse of the Mechanisms of Ion Homeostasis during Salt Stress. J. Exp. Bot. 1999, 50, 1023–1036. [Google Scholar] [CrossRef]
- Porcel, R.; Bustamante, A.; Ros, R.; Serrano, R.; Mulet Salort, J.M. BvCOLD1: A Novel Aquaporin from Sugar Beet (Beta vulgaris L.) Involved in Boron Homeostasis and Abiotic Stress. Plant Cell Environ. 2018, 41, 2844–2857. [Google Scholar] [CrossRef]
- Park, M. The Fertilizer Industry; International Fertilizer Industry Association: Cambridge, UK, 2001; ISBN 1855734613. [Google Scholar]
- Chiaiese, P.; Corrado, G.; Colla, G.; Kyriacou, M.C.; Rouphael, Y. Renewable Sources of Plant Biostimulation: Microalgae as a Sustainable Means to Improve Crop Performance. Front. Plant Sci. 2018, 871, 1782. [Google Scholar] [CrossRef]
- Saporta, R.; Bou, C.; Frías, V.; Mulet, J.M. A Method for a Fast Evaluation of the Biostimulant Potential of Different Natural Extracts for Promoting Growth or Tolerance against Abiotic Stress. Agronomy 2019, 9, 143. [Google Scholar] [CrossRef]
- Benito, P.; Ligorio, D.; Bellón, J.; Yenush, L.; Mulet, J.M. A Fast Method to Evaluate in a Combinatorial Manner the Synergistic Effect of Different Biostimulants for Promoting Growth or Tolerance against Abiotic Stress. Plant Methods 2022, 18, 111. [Google Scholar] [CrossRef]
- Taïbi, K.; del Campo, A.D.; Mulet, J.M.; Flors, J.; Aguado, A. Testing Aleppo Pine Seed Sources Response to Climate Change by Using Trial Sites Reflecting Future Conditions. New For. 2014, 45, 603–624. [Google Scholar] [CrossRef]
- Chevilly, S.; Dolz-Edo, L.; López-Nicolás, J.M.; Morcillo, L.; Vilagrosa, A.; Yenush, L.; Mulet, J.M. Physiological and Molecular Characterization of the Differential Response of Broccoli (Brassica oleracea Var. Italica) Cultivars Reveals Limiting Factors for Broccoli Tolerance to Drought Stress. J. Agric. Food Chem. 2021, 69, 10394–10404. [Google Scholar] [CrossRef]
- ter Steege, M.W.; den Ouden, F.M.; Lambers, H.; Stam, P.; Peeters, A.J.M. Genetic and Physiological Architecture of Early Vigor in Aegilops tauschii, the D-Genome Donor of Hexaploid Wheat. A Quantitative Trait Loci Analysis. Plant Physiol. 2005, 139, 1078. [Google Scholar] [CrossRef]
- Sanghamitra, P.; Nanda, N.; Barik, S.R.; Sahoo, S.; Pandit, E.; Bastia, R.; Bagchi, T.B.; Pradhan, S.K. Genetic Structure and Molecular Markers-Trait Association for Physiological Traits Related to Seed Vigour in Rice. Plant Gene 2021, 28, 100338. [Google Scholar] [CrossRef]
- Rebolledo, M.C.; Luquet, D.; Courtois, B.; Henry, A.; Soulié, J.-C.; Rouan, L.; Dingkuhn, M.; Rebolledo, M.C.; Luquet, D.; Courtois, B.; et al. Can Early Vigour Occur in Combination with Drought Tolerance and Efficient Water Use in Rice Genotypes? Funct. Plant Biol. 2013, 40, 582–594. [Google Scholar] [CrossRef]
- Mulet, J.M. The appeal-to-nature fallacy homeopathy and biodynamic agriculture in official eu regulations. Metode Sci. Stud. J. 2018, 2018, 173–179. [Google Scholar] [CrossRef]
- Muhie, S.H. Plant Biostimulants in Organic Horticulture: A Review. J. Plant Growth Regul. 2022, 1–13. [Google Scholar] [CrossRef]
- Oleszek, W.; Sitek, M.; Stochmal, A.; Piacente, S.; Pizza, C.; Cheeke, P. Steroidal Saponins of Yucca schidigera Roezl. J. Agric. Food Chem. 2001, 49, 4392–4396. [Google Scholar] [CrossRef]
- van Bruggen, A.H.C.; Gamliel, A.; Finckh, M.R. Plant Disease Management in Organic Farming Systems. Pest Manag. Sci. 2016, 72, 30–44. [Google Scholar] [CrossRef]
- la Torre, A.; Righi, L.; Iovino, V.; Battaglia, V. Control of Late Blight in Organic Farming with Low Copper Dosages or Natural Products as Alternatives to Copper. Eur. J. Plant Pathol. 2019, 155, 769–778. [Google Scholar] [CrossRef]
- Zhang, S.; Shu, J.; Xue, H.; Zhang, W.; Zhang, Y.; Liu, Y.; Fang, L.; Wang, Y.; Wang, H. The Gut Microbiota in Camellia Weevils Are Influenced by Plant Secondary Metabolites and Contribute to Saponin Degradation. mSystems 2020, 5, e00692-19. [Google Scholar] [CrossRef]
- Jiang, X.; Cao, Y.; Jørgensen, L.V.G.; Strobel, B.W.; Hansen, H.C.B.; Cedergreen, N. Where Does the Toxicity Come from in Saponin Extract? Chemosphere 2018, 204, 243–250. [Google Scholar] [CrossRef]
- das Laha, S.; Dutta, S.; Schäffner, A.R.; Das, M. Gene Duplication and Stress Genomics in Brassicas: Current Understanding and Future Prospects. J. Plant Physiol. 2020, 255, 153293. [Google Scholar] [CrossRef] [PubMed]
- Locascio, A.; Marqués, M.C.; García-Martínez, G.; Corratgé-Faillie, C.; Andrés-Colás, N.; Rubio, L.; Fernández, J.A.; Véry, A.A.; Mulet, J.M.; Yenush, L. BCL2-ASSOCIATED ATHANOGENE4 Regulates the KAT1 Potassium Channel and Controls Stomatal Movement. Plant Physiol. 2019, 181, 1277–1294. [Google Scholar] [CrossRef]
- Chevilly, S.; Dolz-Edo, L.; Morcillo, L.; Vilagrosa, A.; López-Nicolás, J.M.; Yenush, L.; Mulet, J.M. Identification of Distinctive Physiological and Molecular Responses to Salt Stress among Tolerant and Sensitive Cultivars of Broccoli (Brassica oleracea Var. Italica). BMC Plant Biol. 2021, 21, 488. [Google Scholar] [CrossRef]
- Mulet, J.M.; Alejandro, S.; Romero, C.; Serrano, R. The Trehalose pathway and intracellular glucose phosphates as modulators of potassium transport and general cation homeostasis in yeast. Yeast 2004, 21, 569–582. [Google Scholar] [CrossRef] [PubMed]

Disclaimer/Publisher’s Note: The statements, opinions and data contained in all publications are solely those of the individual author(s) and contributor(s) and not of MDPI and/or the editor(s). MDPI and/or the editor(s) disclaim responsibility for any injury to people or property resulting from any ideas, methods, instructions or products referred to in the content. |
© 2023 by the authors. Licensee MDPI, Basel, Switzerland. This article is an open access article distributed under the terms and conditions of the Creative Commons Attribution (CC BY) license (https://creativecommons.org/licenses/by/4.0/).
Share and Cite
Benito, P.; Ligorio, D.; Bellón, J.; Yenush, L.; Mulet, J.M. Use of Yucca (Yucca schidigera) Extracts as Biostimulants to Promote Germination and Early Vigor and as Natural Fungicides. Plants 2023, 12, 274. https://doi.org/10.3390/plants12020274
Benito P, Ligorio D, Bellón J, Yenush L, Mulet JM. Use of Yucca (Yucca schidigera) Extracts as Biostimulants to Promote Germination and Early Vigor and as Natural Fungicides. Plants. 2023; 12(2):274. https://doi.org/10.3390/plants12020274
Chicago/Turabian StyleBenito, Patricia, Daniele Ligorio, Javier Bellón, Lynne Yenush, and José M. Mulet. 2023. "Use of Yucca (Yucca schidigera) Extracts as Biostimulants to Promote Germination and Early Vigor and as Natural Fungicides" Plants 12, no. 2: 274. https://doi.org/10.3390/plants12020274
APA StyleBenito, P., Ligorio, D., Bellón, J., Yenush, L., & Mulet, J. M. (2023). Use of Yucca (Yucca schidigera) Extracts as Biostimulants to Promote Germination and Early Vigor and as Natural Fungicides. Plants, 12(2), 274. https://doi.org/10.3390/plants12020274

